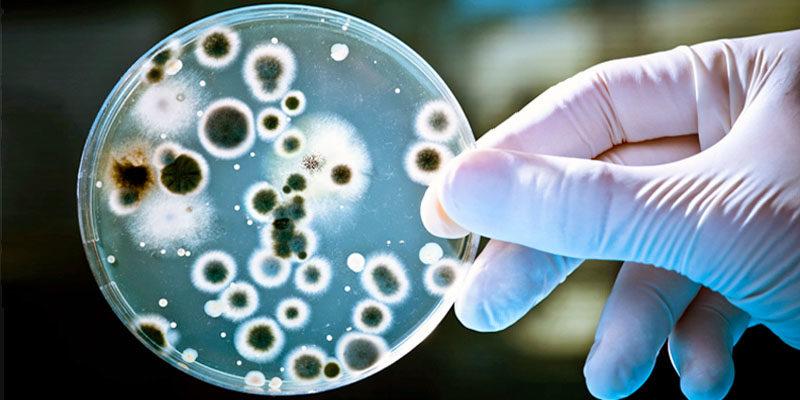

Llegó al país un nuevo antibiótico para el tratamiento de bacterias multirresistentes
Ya se encuentra disponible en nuestro país un nuevo antibiótico para el tratamiento de pacientes adultos internados con infecciones graves provocadas por bacterias Gram-negativas aeróbicas multirresistentes. A partir de la combinación de las drogas ceftazidima y avibactam, esta terapia demostró una amplia eficacia para hacer frente a bacterias resistentes a las terapias disponibles.
Dentro de las bacterias Gram-negativas, la Klebsiella pneumoniae resistente a Carbapenems (KPC), es uno de los patógenos que presentan mayor preocupación ya que ha sido detectado en las 24 provincias del país, representando el 30,2% de los casos de Klebsiella pneumoniae confirmados. La KPC provoca infecciones asociadas con altas tasas de morbilidad y mortalidad, y es resistente a casi todos los antibióticos disponibles.
Como parte de su mecanismo de acción, avibactam (de la familia de los inhibidores de la enzima ´betalactamasa´, producida por las bacterias para eludir el efecto de los antimicrobianos betalactámicos) permite restaurar el mecanismo de acción de la ceftazidima (una droga de la clase de las cefalosporinas, que forma parte del grupo de los betalactámicos) para luchar contra algunos de los agentes patógenos Gram-negativos más resistentes, que son motivo de preocupación sanitaria a nivel mundial.
Entre otras, la nueva combinación está indicada para infecciones intra-abdominales complicadas, infecciones complejas del tracto urinario y neumonías adquiridas en el ámbito hospitalario, como por ejemplo la neumonía asociada al uso de respiradores.
Además, la combinación de ceftazidima-avibactam, está indicada para el tratamiento de infecciones graves por Gram-negativos en pacientes que han agotado las demás opciones terapéuticas. Es decir que representa un importante avance terapéutico pues puede emplearse en diversos escenarios, especialmente cuando un tratamiento antibiótico fracasa producto de la resistencia bacteriana, poniendo en riesgo la vida del paciente.
Según los estudios clínicos realizados, la combinación de ceftazidima-avibactam demostró superioridad respecto a otros tratamientos para el manejo de infecciones provocadas por Klebsiella pneumoniae resistente a Carbapenems (KPC), ya que disminuye significativamente los índices de mortalidad y estadía hospitalaria. Por otra parte, también se observó que el empleo de este nuevo antibiótico aumenta la tasa de pacientes que son externados al domicilio, es decir, que disminuye la cantidad de aquellos que son derivados a centros de rehabilitación.
En este contexto, la eficacia de ceftazidima-avibactam en actividad in vitro contra Klebsiella pneumoniae resistente a Carbapenems (KPC) y otras enterobacterias, mostró resultados determinantes en comparación con Colistin, reduciendo un 30% de las muertes que pueden ocurrir entre un 50%-90% de los pacientes que sufren este tipo de infecciones.
A su vez, esta terapia innovadora permite una disminución en la cantidad de antibióticos administrados. Hoy, permite la biterapia para casos que, hasta ahora, requerían hasta 5 terapias con diferentes tipos de antimicrobianos para un mismo tratamiento, con la consecuente disminución en los costos hospitalarios.
¨Estamos muy entusiasmados con el lanzamiento de esta nueva alternativa terapéutica en Argentina -manifestó el infectólogo Dr. Francisco Nacinovich, jefe de Infectología en el Instituto Cardiovascular de Buenos Aires (ICBA) e integrante de Stamboulian Servicios de Salud-. La combinación de ceftazidima y avibactam viene a cubrir una demanda muy esperada por la comunidad médica ya que es una herramienta segura y efectiva contra un rango de gérmenes de difícil tratamiento y que representan un serio y creciente problema de salud en nuestro país¨.
Un informe presentado recientemente por la Organización Mundial de la Salud (OMS) incluye, por primera vez, una lista de patógenos que son prioridad mundial para orientar los esfuerzos de la ciencia en materia de investigación y desarrollo, entre las que se incluyen las bacterias Gram-negativas que esta nueva combinación demostró combatir.
Actualmente, el mayor número de infecciones provocadas por estas bacterias se presenta en los pacientes que están hospitalizados en unidades de cuidados intensivos, que requieren procedimientos quirúrgicos, que son recién nacidos y/o se encuentran heridos por quemaduras.
Según una base de datos sobre la eficacia de tratamientos con antibióticos y nuevos patrones de resistencia realizada en más de 60 países, se registró un incremento en la resistencia de algunas bacterias Gram-negativas en Latinoamérica de alrededor de un 14% en 2011 a 29% en 2016. En este contexto, la Argentina no está ajena a esta realidad.
¨En la Argentina, se observa una necesidad creciente de terapias para el tratamiento de bacterias multirresistentes, especialmente en el ámbito hospitalario. El rápido aumento y la gran proliferación de patógenos Gram-negativos es un desafío enorme para la ciencia¨, sostuvo el Dr. Fernando Pasteran, especialista en microbiología clínica y profesional adjunto del Servicio de Antimicrobianos, Laboratorio Nacional de Referencia, Instituto Nacional de Enfermedades Infecciosas, INEI-ANLIS Dr. Carlos G. Malbrán. ¨Necesitamos contar con nuevos antibióticos para luchar contra las infecciones hospitalarias causadas por gérmenes resistentes, ya que por el momento no disponemos de suficientes alternativas terapéuticas efectivas y tolerables para el paciente¨, concluyó.
Entre los principales efectos adversos reportados por el uso de la terapia combinada (n=2024 en siete estudios clínicos en fase II y III) en el 5% o más de los pacientes se observó la presencia de anticuerpos (prueba de Coombs) que precipitan la desaparición de los glóbulos rojos (anemia hemolítica), náuseas y diarrea. Los cuadros de diarrea y náuseas fueron, en general, en grado leve o moderado de intensidad.
Acerca de la resistencia antimicrobiana (RAM)
Actualmente, la resistencia antimicrobiana es uno de los problemas de salud pública más preocupantes del mundo. Se la considera responsable cada año de cerca de 700 mil casos fatales mientras que, según las estimaciones proyectadas para el 2050, fallecerán anualmente por esta causa 10 millones de personas.
Sólo en Europa, la RAM es responsable de 25 mil muertes al año, donde dos tercios de los casos fatales registrados son provocados por bacterias Gram-negativas como la Escherichia coli. El impacto clínico de las infecciones multirresistentes tiene un costo estimado de 1.500 millones de euros por año.
Entre las recomendaciones para disminuir el impacto de la resistencia antimicrobiana, Nacinovich recomendó ¨evitar el mal uso de antibióticos y promover un empleo responsable de los mismos, practicar siempre el lavado de manos, concretar el alta temprana de los pacientes que se encuentren estables, y respetar las medidas para el control de las infecciones hospitalarias (llamadas actualmente ´asociadas a los cuidados de la salud´) que se implementan en las instituciones. Además, la higiene periódica de las superficies y los elementos médicos son pilares fundamentales¨.

Por buenapraxis
Por buenapraxis